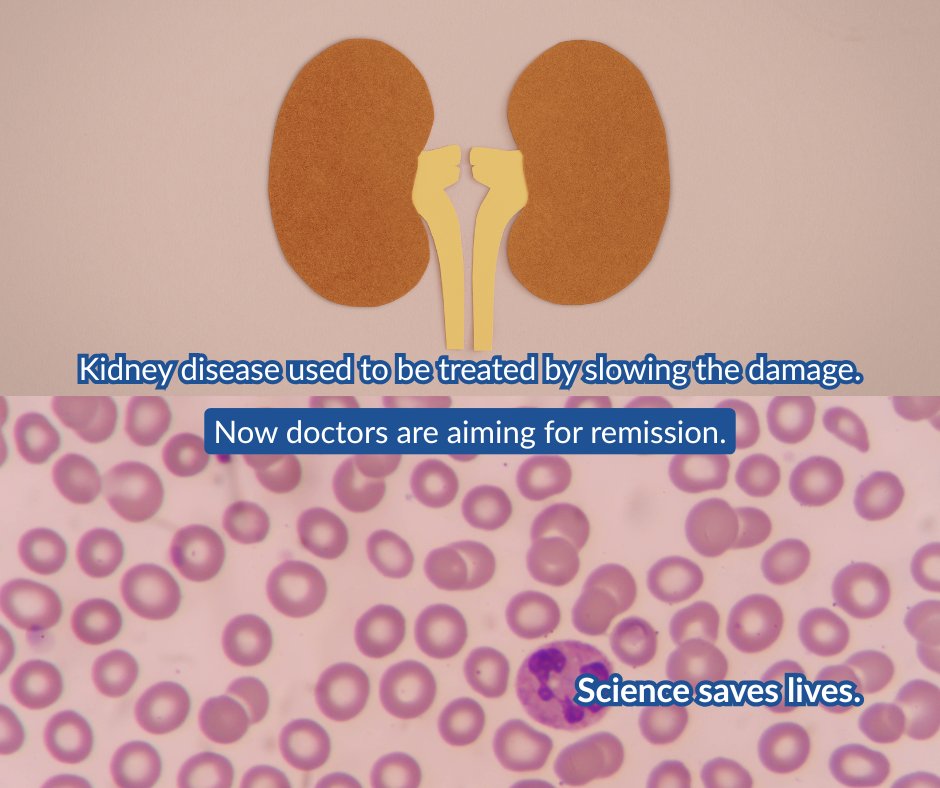
ScienceSaves tweet media

ScienceSaves
1.7K posts

ScienceSaves
@ScienceSavesOrg
Because science saves lives, and that’s something worth celebrating. Join us in building a culture of gratitude for science.
เข้าร่วม Ağustos 2020
414 กำลังติดตาม1.1K ผู้ติดตาม

March 26, 1953.
Polio went from a fear every parent lived with…
to something we could fight back against.
That’s the day we chose.
#ScienceAppreciationDay

English

A three-month-old was losing mobility by the day.
There was a treatment.
It was denied multiple times.
It’s now approved:
clickondetroit.com/news/2026/03/1…

English

Jacqueline made this herself.
Same disease. Different treatment.
Both are still here.
#ScienceSaves
English

No pain. No urgency. Just… nothing.
A ruptured appendix almost killed him.
Five hours of surgery saved him.
He’s 86 now. Still going.
“Science—and a lot of people—saved my life.”
March 26. #ScienceAppreciationDay

English

“I was diagnosed with glaucoma at 12.
Now I measure my own eye pressure and share that data with my doctor to prevent further vision loss.
I’m in school. Studying neuropsychology.
Science makes that possible.”
— Jhansi
#ScienceSaves

English

Delaware just joined.
This keeps growing for a reason.
A vaccine.
A procedure.
A diagnosis caught in time.
A lot of us are here because science showed up at the right time.
March 26.
#ScienceSaves #ScienceAppreciationDay
English

She called to cancel an appointment. They heard a heart attack.
Paramedics were at her door within minutes.
“I probably would have stayed home.”
Science saving lives in action:
ky3.com/2026/03/21/sav…

English

Five days out, and this is already spreading.
States are recognizing March 26 as National #ScienceAppreciationDay because a lot of us are alive thanks to it.
If that’s your story (or someone you love), you’re part of this too.
English

Artificial hearts kept failing for the same reason:
Too complex.
Now researchers have stopped trying to copy the heart.
One spinning rotor. No valves. Less to break.
For the first time in decades, there’s real momentum:
facs.org/for-medical-pr…
English

May 17, 2019: septic shock.
Machines kept her alive.
She made it through.
This is her later, still in recovery, still here.
Not a perfect ending.
But a very real one.
#ScienceSaves #SepticShock #CriticalCare


English

Connecticut. Washington, D.C. Washington state.
Now recognizing National Science Appreciation Day for the machines, medicines, and breakthroughs people rely on every day.
March 26.
See who else is participating:
sciencesaves.org/whos-celebrati…
#ScienceSaves #PublicHealth #STEM

English

Science saves lives, often by making tragedies disappear.
In the early 1950s, diseases like polio filled hospitals with children fighting to breathe. Vaccines changed that.
A U.S. judge just blocked an effort to weaken the childhood vaccine schedule:
reuters.com/world/us-judge…

English

"Don’t let this disease start again.”
David was three when polio put him in the hospital for a month.
He could only see his parents through a screen door.
Today one of his legs is half the size of the other.
Vaccines changed the future for millions of families. #ScienceSaves

English

Kidney disease treatment used to focus on slowing the damage.
Now new therapies—like monoclonal antibodies—are starting to aim for remission.
Doctors are beginning to treat the immune causes behind kidney disease, not just the symptoms:
timesofindia.indiatimes.com/city/madurai/n…
English


